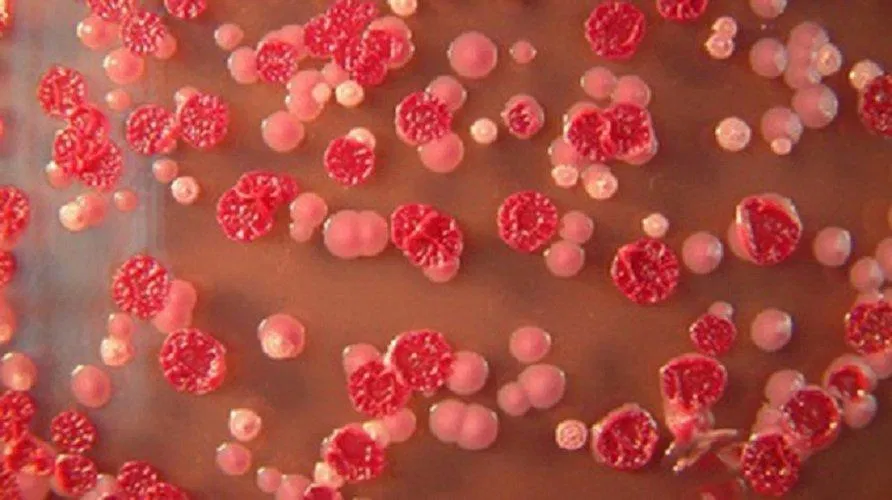
Bệnh Whitmore gây ra các triệu chứng nghiêm trọng cho người bệnh (Ảnh Internet)

Gần đây, số lượng người mắc bệnh Whitmore đang ngày càng tăng cao do biến chứng cũng như biểu hiện đa dạng của nó khi bị nhiễm bệnh. Cùng BlogAnChoi tìm hiểu kĩ về loại bệnh này và cách phòng chống bệnh Whitmore ở bài viết dưới đây nhé!
Bệnh Whitmore là bệnh gì?
Bệnh Whitmore (bệnh Melioidosis) là một trong những căn bệnh truyền nhiễm có khả năng lây nhiễm cho cả người hoặc động vật. Chúng thường tồn tại trên đất, nguồn nước bị ô nhiễm rồi lây lan qua các vết thương hở, xâm nhập và làm giảm hệ thống miễn dịch của chúng ta gây bệnh nặng. Trong trường hợp không chữa trị kịp thời, người bệnh có thể chết vì nhiễm trùng máu nặng và tổn thương các vùng nội tạng liên quan.

Nguyên nhân gây ra bệnh Whitmore
Căn bệnh Whitmore bắt nguồn từ vi khuẩn Burkholderia pseudomallei – một loại vi khuẩn tồn tại trong vùng đất ẩm, xuất hiện nhiều ở các khu vực nhiệt đới hoặc cận nhiệt đới. Chúng thường có những biểu hiện dễ nhầm lẫn với các bệnh liên quan đến nội tạng như lao phổi, áp-xe gan,… ở những nơi bị thương thì xuất hiện mụn mủ, lở loét nghiêm trọng.

Tuy đã được phát hiện từ lâu nhưng bệnh Whitmore hiện nay đang có dấu hiệu ngày càng tăng do tỉ lệ người mắc nhiễm khá cao, đi kèm với triệu chứng bệnh ngày một nặng hơn. Mặc dù nó không có khả năng trở thành dịch bệnh nhưng việc chống lại một số loại kháng sinh chữa bệnh cũng khiến việc điều trị trở nên khó khăn hơn.
Bệnh Whitmore thường gặp ở đâu? Cách thức lây lan của nguồn bệnh
Bệnh Whitmore thường tồn tại ở trong đất ẩm, tại các nguồn nước nhiễm bẩn. Khi chúng ta không may tiếp xúc với bùn đất bẩn hoặc dính nước mưa, hay chẳng may bị nhiễm trùng da do các vết xước thì khả năng mắc căn bệnh này sẽ cao hơn. Đặc biệt, với những người có tiền sử bệnh mãn tính trước đó như bệnh tiểu đường, suy gan, suy thận,… sẽ khó khăn trong việc điều trị bệnh hơn nếu họ không may nhiễm bệnh Whitmore.

Như đã nói ở trên, không chỉ con người các loài động vật như dê, cừu, bò, gà, lợn,… đều có khả năng mắc bệnh Whitmore như thường. Tại các khu vực có khí hậu nóng ẩm nhiệt đới như Đông Nam Á, vi khuẩn của bệnh dễ dàng sinh sôi nảy nở hơn và tăng khả năng lây bệnh cho những người khác.
Triệu chứng của bệnh Whitmore
Có nhiều loại vi khuẩn melioidosis khác nhau nên việc chẩn đoán ra triệu chứng của bệnh Whitmore cũng gặp nhiều khó khăn. Tuy nhiên có thể chỉ ra các triệu chứng cơ bản như sau:
- Thời gian ủ bệnh: 9 ngày, nhưng tùy vào cơ địa của mỗi người nên có thể lên tới 21 ngày.
- Nhiễm trùng cục bộ: đau hoặc sưng cục bộ. Người nhiễm có biểu hiện sốt cao đồng thời xuất hiện các vết loét da hoặc áp-xe trên diện rộng.
- Nhiễm trùng phổi: người bệnh bắt đầu có triệu chứng chán ăn, mệt mỏi, ho nhiều, tiếp đến đau nhức các cơ và sốt cao. Do biểu hiện có phần giống với lao phổi và viêm phổi nên khiến người bệnh dễ bị nhầm lẫn ở giai đoạn này.

- Nhiễm trùng máu: thường thì đến giai đoạn này các bệnh nhân đã có tiền sử bị bệnh tiểu đường hay suy gan, suy thận có nguy cơ mắc nhiễm cao hơn các bệnh nhân khác, đồng thời sẽ gặp các triệu chứng như suy hô hấp, khó chịu ở vùng bụng, đau khớp chân tay, sốt cao,… Vì các triệu chứng nhiễm trùng đã khá nặng nên họ có nguy cơ bị sốc nhiễm trùng rất cao, gây nguy hiểm cho các bộ phận trên cơ thể còn lại.
- Nhiễm trùng toàn thân: đây là giai đoạn cuối cùng của quá trình hình thành bệnh Whitmore. Ở giai đoạn này, tất cả các cơ quan trên cơ thể như gan, lá lách, tuyến tiền liệt, não,… đều bị ảnh hưởng gây nên các triệu chứng như động kinh, sốt cao không thuyên giảm, đau cơ ngực và dạ dày, sụt cân nghiêm trọng so cảm giác chán ăn.
Cách điều trị bệnh Whitmore
Khi nhận thấy các biểu hiện của bệnh Whitmore, bạn cần ngay lập tức đến các cơ sở y tế uy tín làm xét nghiệm kiểm tra để tìm ra nguồn bệnh cũng như cách chữa trị.
Do có nhiều loại Melioidosism khác nhau mà phương pháp điều trị và các loại thuốc được sử dụng cũng khác nhau. Tuy nhiên, hầu hết bệnh Whitmore đều được điều trị theo cách sử dụng kháng sinh theo đường tiêm tĩnh mạch từ 10 – 14 ngày, tiếp đó là từ 3 – 6 tháng sử dụng kháng sinh theo đường uống.

Giai đoạn từ 10 -14 ngày có thể sử dụng các loại kháng sinh để tiêm như:
- Ceftazidime dùng mỗi 6 – 8 giờ/lần.
- Meropenem dùng mỗi 8 giờ/lần.
Giai đoạn từ 3 – 6 tháng có thể sử dụng các loại kháng sinh để uống như:
- Trimethoprim-sulfamethoxazole uống mỗi 12 giờ/lần.
- Amoxicillin/axit clavulanic (co-amoxiclav) được thực hiện mỗi 8 giờ/lần.

Cách phòng ngừa bệnh Whitmore
Hiện nay, bệnh Whitmore chưa có vắc-xin phòng bệnh nên mọi người có thể phòng bệnh bằng các cách như sau:
- Tránh tiếp xúc với những nơi bị ô nhiễm nặng, ao tù, nước đọng.
- Sát trùng sạch sẽ và băng bó cẩn thận các vết thương hở, để tránh bị nhiễm trùng.
- Nếu phải làm việc ở ngoài trời nhiều giờ liền, cần phải mặc đồ bảo hộ đầy đủ, tránh nguy cơ lây nhiễm từ đất cát, hay bụi bẩn xung quanh.
- Các bệnh nhân có nguy cơ nhiễm cao như bệnh nhân tiểu đường, suy gan, suy thận,… cần phải điều trị và bảo vệ kĩ càng để tránh bị nhiễm bệnh.
- Nếu cảm thấy có các triệu chứng bất thường nào liên quan đến bệnh Whitmore, ngay lập tức đi đến các cơ quan y tế uy tín để kiểm tra.
Các bạn có thể tìm kiếm thêm các thông tin liên quan đến sức khỏe tại đây:
- Bệnh Whitmore: Vi khuẩn ăn thịt người?
- Sốt rét: Triệu chứng, nguyên nhân và cách điều trị
- Hẹp van tim: Nguyên nhân, triệu chứng, điều trị và cách phòng ngừa


































